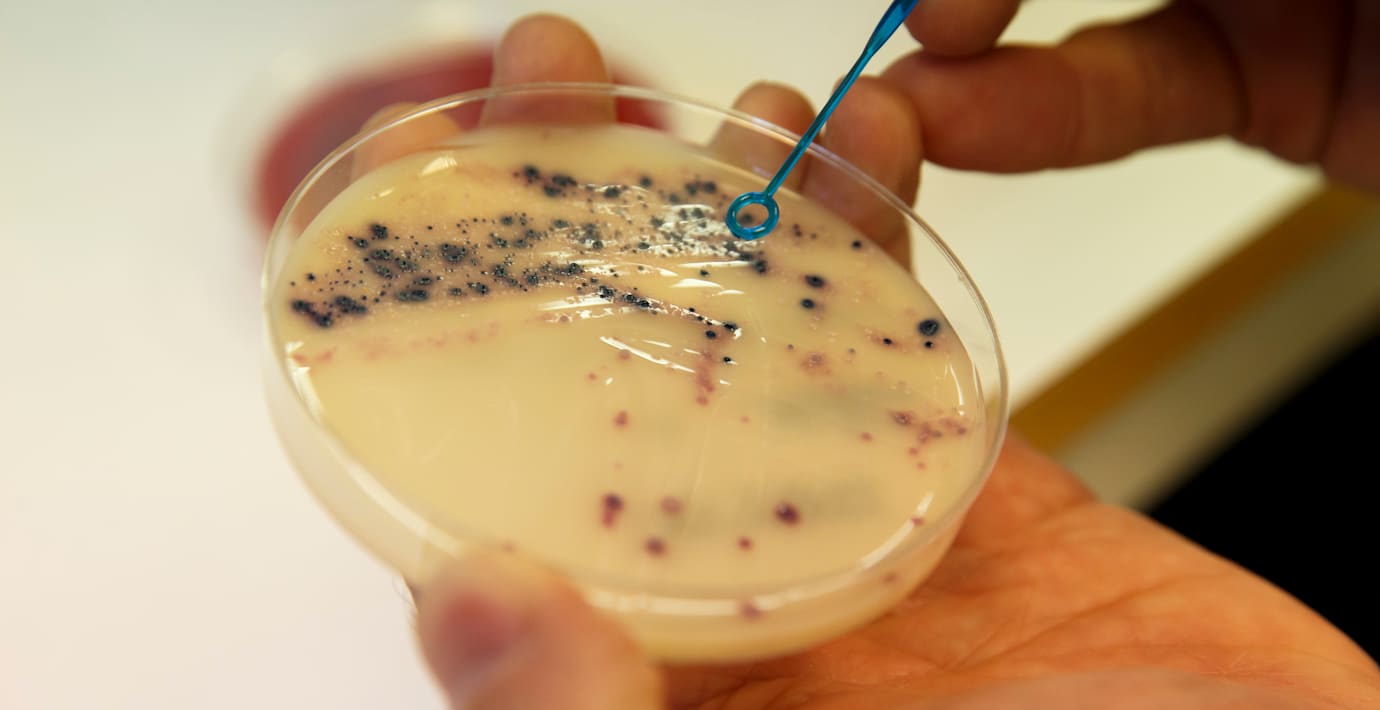

Regeringen sätter nya mål för utskrivningen av antibiotika
Regeringen inför nya mål med syfte att minska utbredningen av antibiotikaresistens hos bakterier, skriver TT. Bland annat sätts ett mål om att högst 250 antibiotikarecept per tusen invånare ska skrivas ut fram till 2035. Det är ungefär samma nivå som Sverige ligger på i dag.
– I nästan 100 år har antibiotika varit grunden för modern sjukvård, men en av mänsklighetens största landvinningar håller på att glida oss ur händerna, säger socialminister Jakob Forssmed (KD) på en pressträff.
I regeringens nya mål ingår också minskade infektioner inom vården och att barnvaccinationstäckningen inte får understiga 95 procent.

Se pressträffen här
Omni är politiskt obundna och oberoende. Vi strävar efter att ge fler perspektiv på nyheterna. Har du frågor eller synpunkter kring vår rapportering? Kontakta redaktionen



